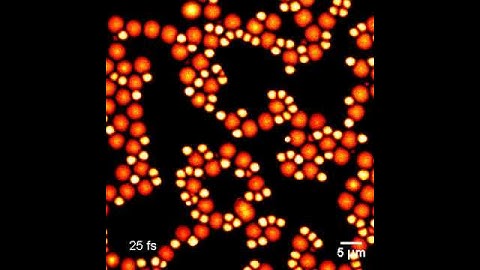
Two-Color (Non-Degenerate) TPF Imaging

⬇ DOWNLOAD NOW
Kalau muncul iklan pop-up, tutup lalu klik tombol kembali
Download lagu What Are "Degenerate Triangles"? #shorts secara gratis hanya untuk keperluan promosi. Dukung artis favorit kamu dengan membeli musik original di iTunes atau platform resmi lainnya.
 Degenerate Triangles
Degenerate Triangles
 Degenerate and Non Degenerate Triangles
Degenerate and Non Degenerate Triangles
 The COOLEST TRIANGLE of ALL TIME... #shorts
The COOLEST TRIANGLE of ALL TIME... #shorts
 Embrace It Or Degenerate.
Embrace It Or Degenerate.
Two-Color (Non-Degenerate) TPF Imaging
Two-Color (Non-Degenerate) TPF Imaging
 A. Bad Triangle | Educational Codeforces Round 93 (Rated for Div 2) | Non Degenerate Triangle
A. Bad Triangle | Educational Codeforces Round 93 (Rated for Div 2) | Non Degenerate Triangle
 random information about halo mod tools
random information about halo mod tools
 Word to learn : Brawl #britishenglish #ingles #englishgrammar
Word to learn : Brawl #britishenglish #ingles #englishgrammar